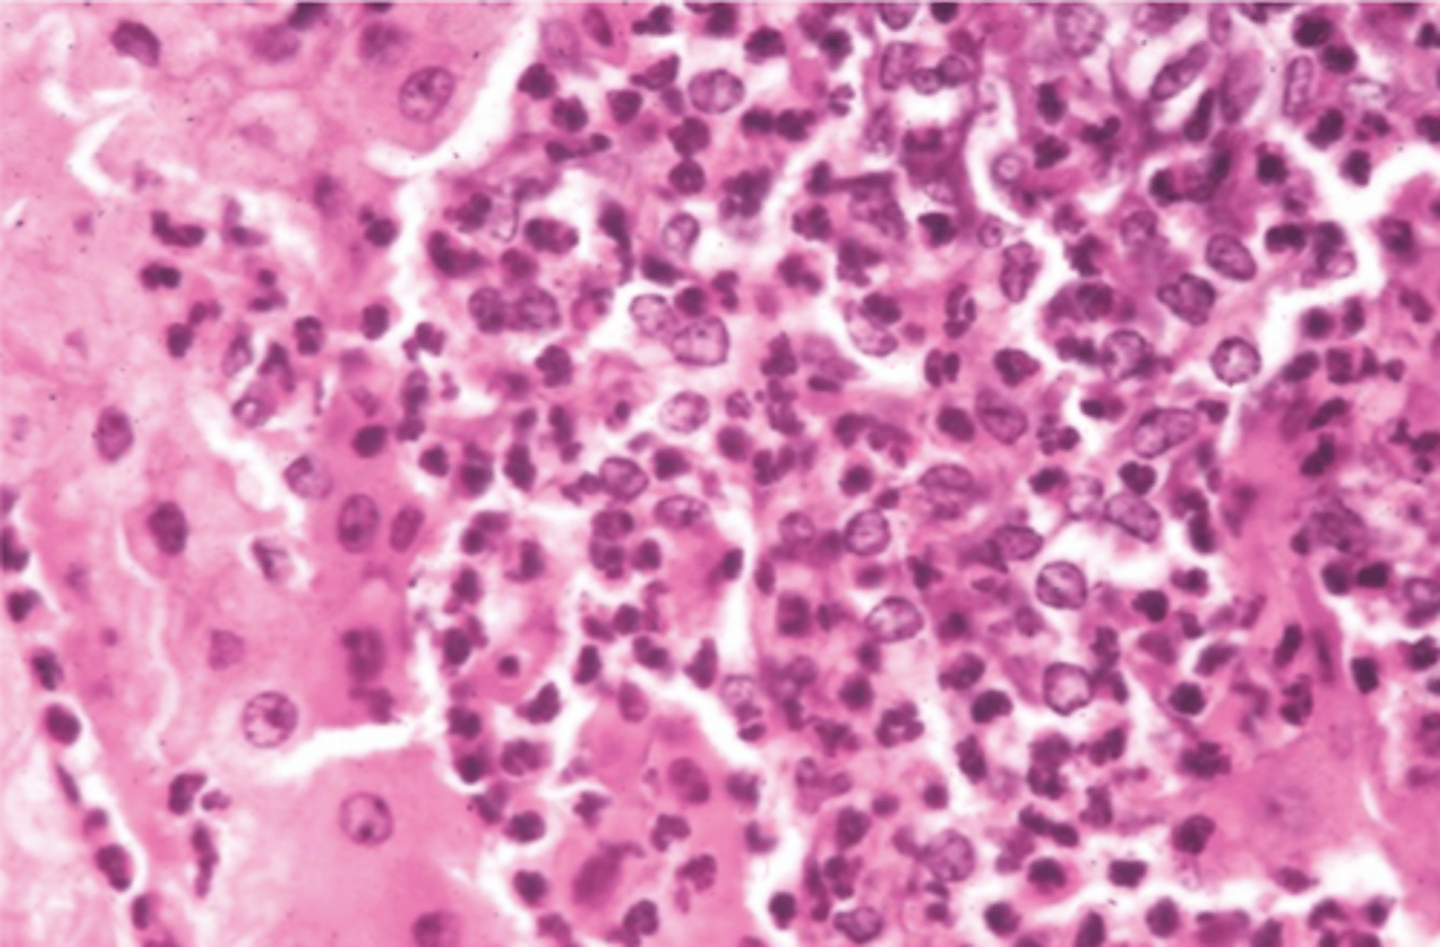
<p>hígado.</p><p>¿diagnóstico morfológico y etiológico?</p>

1/107
Looks like no tags are added yet.
Name | Mastery | Learn | Test | Matching | Spaced | Call with Kai |
|---|
No analytics yet
Send a link to your students to track their progress
glositis ulcerativa
diagnosis morfológica:

no- es inespecífica
secundaria a muchas otras enfermedades
¿la estomatitis erosiva/ ulcerativa es específica de algún patología?
heridas
quemaduras
infecciones víricas (virus de la estomatitis vesicular)
la estomatitis vesicular puede ser causado por:
estomatitis vesicular
¿cómo se llama morfológicamente ampollas (blisters) con lesiones erosivas y ulcerativas en la boca?
ampollas que explotan y vemos lesiones erosivas y ulcerativas
¿cómo se ve estomatitis vesicular macroscópicamente?
degeneración hidrópica o vacuolar de las células epiteliales
¿cómo se ve estomatitis vesicular microscópicamente?
estomatitis vesicular
con una muestra de la boca de un caballo, vemos degeneración hidrópica y vacuolar de las células epiteliales. ¿qué es la diagnóstica morfológica?
glositis ulcerativa fibrinonecrótica
diagnosis morfológica:

estomatitis fúngica, por Candida albicans, causando gruesas membranas de color amarillento-blanquecino en la boca/ lengua
¿qué es estomatitis necrótico-fibrinosa/ necrótica-difteroide / pseudomembranosa?
estomatitis necrótico-fibrinosa/ necrótica-difteroide / pseudomembranosa
¿una infección por Candida albicans produce qué patología de la boca?
Candida albicans
estomatitis necrótico-fibrinosa/ necrótica-difteroide / pseudomembranosa es causado por :
estomatitis necrótico-fibrinosa/ necrótica-difteroide / pseudomembranosa
etiología: Candida albicans
muestra de la lengua.
¿diagnóstico?

Candida albicans
esofagitis necrótico-fibrinosa/ necrótica-difteroide / pseudomembranosa tiene la agente etiológica de:
infección por Candida albicans, provocado por tratamientos antibióticos prolongados, inanición, esofagitis reflujo, complicaciones de esofagitis en animales jóvenes
¿qué causa esofagitis necrótico-fibrinosa/ necrótica-difteroide / pseudomembranosa ?
necrótico-fibrinosa/ necrótica-difteroide / pseudomembranosa
¿Candida albicans provoca qué tipo de inflamación?
esofagitis ulcerativa
¿diagnóstico morfológico?

erosiva: afectando el epitelio
ulcerativa: afectando la lámina propia y submucosa también
¿qué es la diferencia entre esofagitis erosiva y ulcerativa?
agentes infecciosos
agentes cáusticos
esofagitis de reflujo
manejo (sondaje)
¿qué causa esofagitis ulcerativa o erosiva?
esofagitis ulcerativa o erosiva
erosiva si afecta sólo el epitelio
ulcerativa si también afecta a la lámina propia y submucosa
microscópicamente, un aspecto crateriforme del esófago se llama:
esofagitis ulcerativa
¿diagnóstico morfológico?

esofagitis ulcerativa
causa: cuerpo extraño (pq vemos necrosis por falta de sangre, que está causado por obstrucción)
¿diagnóstico morfológico?
¿causa probable?

post mortem: sin hemorragias, peritonitis, inflamación, etc
ante mortem: hemorragia, peritonitis, etc
¿cómo diferenciamos entre roturas gástricas post y ante mortem?
post mortem: sin hemorragia, inflamación, peritonitis, etc
¿rotura gástrica ante o post mortem?

ante mortem: hemorragia
¿rotura gástrica ante o post mortem?

ante mortem: peritonitis
¿rotura gástrica ante o post mortem?

24-48h
¿cuanto tiempo se clasifica una gastritis como aguda?
primarias:
- agentes infecciosos
- fármacos
- tóxicos
- traumas
- estrés
- alérgenos
- cambios bruscos de la dieta
secundarias:
- fallo renal → uremia
- enfermedades hepáticas agudas o crónicas
- septicemias
¿qué causa una gastritis aguda?
crónica
= gastritis catarral crónica hipertrófica
¿una gastritis aguda o crónica será hipertrófica?
un desequilibrio de la secreción ácida y protección de la mucosa, por:
- acidificación gástrica elevada (por fármacos, alimentación ácido)
- trauma en el epitelio (por reflujo biliar, solventes lipídicos)
- alteraciones del flujo sanguíneo local → isquemia
- fármacos antiinflamatorios esteroides y AINEs
- Gasterophilus
¿qué causa gastritis ulcerativa?
porque altera el flujo sanguíneo local, causando isquemia
¿por qué el estrés puede causar gastritis ulcerativa?
porque causan:
- ↓ secreción de protectores
- ↓ prostaglandina sintetasa → ↓ el tono vascular y perfusión → isquemia → necrosis y ulceración
¿por qué fármacos antiinflamatorios (esteroides y AINEs) pueden causar gastritis ulcerativa?
gastritis ulcerativa
¿diagnóstica morfológica?

gastritis ulcerativa
¿diagnóstica morfológica?

Gasterophilus
- ulceras en el parte no glandular
- lesiones crateriformes, y a veces la rotura gástrica
¿qué parásito puede provocar una gastritis ulcerativa?
gastritis ulcerativa por Gasterophilus
¿diagnóstica morfológica y etiológica?

gastritis granulomatosa por Draschia megasotma
¿diagnóstica morfológica y etiológica?

gastritis granulomatosa
¿Draschia megastroma causará qué problema del aparato digestivo?
Draschia megastroma
¿qué parásito causa gastritis granulomatosa?
giro de una asa intestinal alrededor de su eje mesentérico, produciéndose la oclusión intestinal
¿qué es torsión intestinal?
- cuerpo extraño
- parásitos
- movimientos bruscos
- peristaltismos violentos
- lipomas pedunculados
¿qué puede causar una torsión intestinal?
- congestión pasiva local aguda de la asa intestinal afectado
- rotura de vasos/ hemorragias
- necrosis
- peritonitis
¿cómo aparece una torsión intestinal macroscópicamente?
torsión intestinal
¿patología?

lipoma pedunculado → torsión intestinal
¿patología?

lipoma pedunculado → torsión intestinal
¿patología?

estenosis intestinal
¿patología?

una obstrucción de la luz intestinal
una estenosis intestinal es:
cualquier cosa que causa una obstrucción:
- parásitos
- cuerpos extraños (arena, enterolitos)
- coprostasis
¿qué puede causar un estenosis intestinal?
obstrucción/ estenosis intestinal por enterolito
¿patología?

obstrucción/ estenosis intestinal por parascaris
¿patología?

enteritis: inflamación del intestino delgado
colitis: inflamación del intestino grueso
¿qué es la diferencia entre enteritis y colitis?
catarral
fibrinosa
erosiva
ulcerativa
necrótico-difteroide
¿qué son los diferentes tipos inflamación aguda, según sus características morfológicas?
aguda
¿una inflamación necrótico-difteroide es aguda o crónica?
aguda
¿una inflamación catarral es aguda o crónica?
aguda (puede ser cronica tmb)
¿una inflamación fibrinosa es aguda o crónica?
aguda
¿una inflamación erosiva es aguda o crónica?
aguda
¿una inflamación ulcerativa es aguda o crónica?
crónica
¿una inflamación granulomatosa es aguda o crónica?
inflamación granulomatosa
¿qué son los diferentes tipos de inflamaciónes crónicas, según sus características morfológicas?
inflamación del recto
¿qué es proctitis?
inflamación del ciego
¿qué es tiflitis?
gastroenteritis
la inflamación del estómago y intestino se llama:
- bacteria (Clostridium, Clostridioides, Salmonella, Rhodococcus equi, Lawsonia)
- fúngica
- verminosa (Parascaris, Stronglyus)
- disbacteriosis
- fármacos (AINEs, sedantes, anestesia)
- nutricional
- tóxinas (arsenico, cantaridina, ricino)
¿qué son las causas posibles de enteritis/ colitis?
Clostridium perfringens
Clostridium piliforme
Clostridioides difficile
Salmonella
Rhodococcus equi
Lawsonia
¿qué son los agentes bacterianos más comunes del enteritis/ colitis?
si
¿es necesario siempre hacer un cultivo si sospechamos infección bacterial intestinal?
enteritis
etiología: clostridiosis (submucosa engrosada, con aspecto gelatinosa)
diagnóstico morfológico y etiológico"

clostridiosis
¿qué agente etiológico provoca una enteritis con una submucosa engrosada, con aspecto gelatinosa?
enterocolitis necrótica
¿Clostridium perfringens tipo C provocará qué tipo de inflamación intestinal?
enterocolitis necrótica
+ hepatitis y miocarditis
¿Clostridium piliformis provocará qué tipo de inflamación intestinal?
enterocolitis necrótica
¿Clostridioides difficile provocará qué tipo de inflamación intestinal?
enterocolitis necrotizante
(por salmonella)
¿patología morfológica?

enteritis necrótico-fibrinosa
(por salmonella)
¿patología morfológica?

enteritis, por Salmonella (botones pestosos- típicos de salmonella)
¿patología morfológica y etológica?

enteritis piogranulomatosa
Rhodococcus equi
(bacteria pulmonar, que puede llegar al intestino y formar lesiones purulentos y granulomatosos))
¿patología morfológica y etiológica?

enteritis piogranulomatosa
Rhodococcus equi
¿patología morfológica y etológica?

enteritis piogranulomatosa
Rhodococcus equi
¿patología morfológica y etológica?

Parascaris equorum
Strongylus equinus, edentatus, vulgarus
¿qué parásitos son más comunes del tracto intestinal en equino?
Parascaris equorum
¿etiología?

Parascaris equorum
¿etiología?

hemomelasma ilei
parasitaria (por migración de Strongylus)
¿diagnóstico morfológica y etiología?

líneas de migración parasitaria (Strongylus)
¿etiología?

Strongylus vulgaris
arteria mesentérica craneal.
¿etiología?

herpesvirus
¿qué virus más frecuentemente afecta el hígado de caballos?
hepatitis necrotizante
¿herpesvirus causa qué tipo de hepatitis?
macro: focos de necrosis multifocales
micro: focos de necrosis multifocales, y cuerpos de inclusión intranucleares acidófilos
¿cómo se ve un hígado afectado por herpesvirus macro y microscópicamente?
hepatitis necrotizante, por herpesvirus
¿diagnóstico morfológico y etiológico?

hepatitis necrotizante, por herpesvirus
(cuerpos de inclusión intranucleares acidófilos)
hígado.
¿diagnóstico morfológico y etiológico?

hepatitis purulenta
(con abscesos)
¿una infección del hígado por bacterias causará qué tipo de hepatitis?
- vena porta (por intestinos)
- arteria hepática (por bacteremia)
- vena umbilical
- conductos biliares
- migración parasitaria
- extensión directa, desde tejidos adyacentes
¿cómo entran bacterias al hígado?
hepatitis purulenta, por bacteria
¿diagnóstico morfológico y etiológico?

hepatitis purulenta, por bacteria
¿diagnóstico morfológico y etiológico?

hepatitis purulenta, por bacteria
(muchos neutrófilos)
hígado.
¿diagnóstico morfológico y etiológico?
Clostridium piliforme
enfermedad de Tyzzers es una inflamación del hígado causado por:
una hepatitis, por Clostridium piliforme, que afecta principalmente a animales muy jóvenes o inmunodeprimidos.
primero colonizan el intestino, y llegan al hígado a travéz de la vena porta
¿qué es la enfermedad de Tyzzers?
enfermedad de Tyzzers
si Clostridium piliforme llega desde el intestino hacía el hígado, ¿provocará qué enfermedad?
enfermedad de Tyzzers (hepatitis necrotizante)
Clostridium piliforme
hígado.
¿diagnóstico y etiología?

enfermedad de Tyzzers
Clostridium piliforme
(hay bacilos, que solamente se ve con tinciones especiales)
(focos de necrosis con infiltrado de neutrófilos + células mononucleares + bacilos en bordes de la lesión)
hígado.
¿diagnóstico y etiología?

enfermedad de Tyzzers
Clostridium piliforme
(hay bacilos, que solamente se ve con tinciones especiales)
(focos de necrosis con infiltrado de neutrófilos + células mononucleares + bacilos en bordes de la lesión)
hígado.
¿diagnóstico y etiología?

macro: hepatitis + enterocolitis necrotizante
micro: focos de necrosis con infiltrado de neutrófilos + células mononucleares + bacilos en bordes de la lesión
¿cómo se ve la enfermedad de Tyzzers macro y microscópicamente?
Strongylus edentatus, equinus
Fasciola
Parascaris equorum
¿qué parásitos más frecuentemente causan hepatitis?
perihepatitis fibrosa
¿qué tipo de hepatitis causan Strongylus edantatus o equinus?